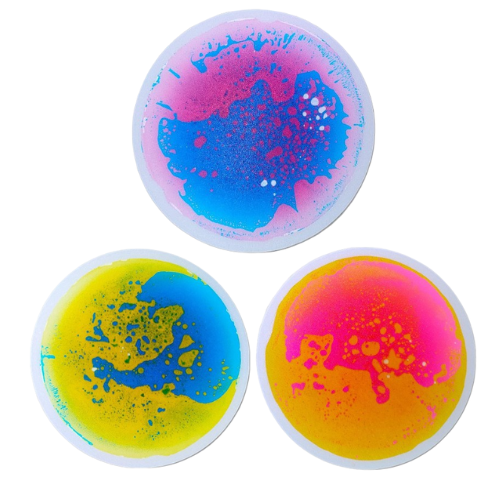
Sensory Liquid Mat

Collection: Therapy Aids
As we discussed the concept of the Neurodiversity Shop with various psychologists and therapists in the field, we found that, just like the rest of us, they also struggle to find everything they need.
So we are starting the process of identifying how we can help and what we can make available.
-
Aroma Ultrasonic Diffuser & Humidifier 500ml
Regular price R 450.00 ZARRegular priceUnit price / perSale price R 450.00 ZAR -
Aroma Ultrasonic Diffuser & Humidifier 300ml
Regular price R 350.00 ZARRegular priceUnit price / perSale price R 350.00 ZARSold out -
Ultrasonic Diffuser & Humidifier with remote 400ml
Regular price R 550.00 ZARRegular priceUnit price / perSale price R 550.00 ZAR -
Pure Essential Oils
Regular price From R 30.00 ZARRegular priceUnit price / perSale price From R 30.00 ZAR -
Sensory Liquid Mat
Regular price R 750.00 ZARRegular priceUnit price / perSale price R 750.00 ZAR